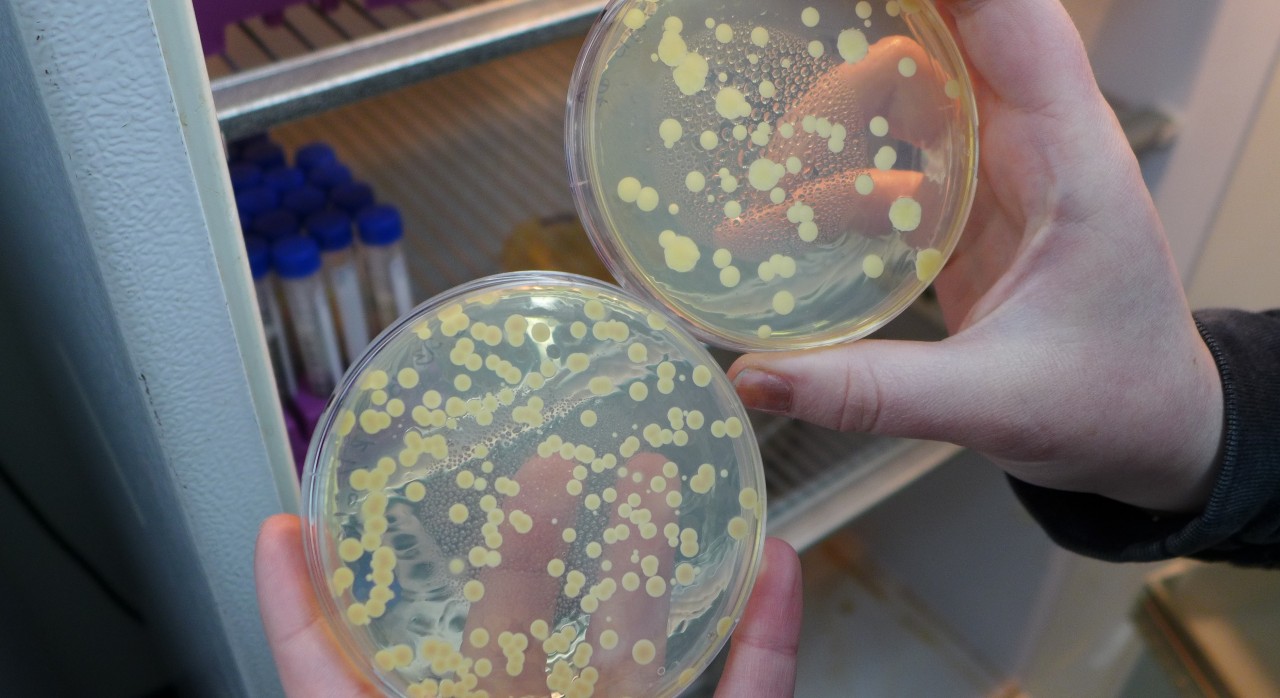

Chris Hittinger names newly discovered yeast for Bucky Badger
When you discover a new organism, you get to name it — but not for yourself. There are rules to the naming business in biology. You can, however, name it for the sponsor of your research. When Chris Hittinger and his group of yeast researchers at the University of Wisconsin-Madison found a rather aggressive yeast, it was natural to name it for the fierce carnivore that is the mascot of his home institution: Bucky Badger.
And so Blastobotrys buckinghamii emerged from the soil of Michigan’s Upper Peninsula to become one of approximately 1,500 known species of yeast. “It was the most aggressive of the eight new species we found,” Hittinger says, “and we thought it was appropriate to name it for Bucky Badger, as it reminded us of Bucky charging down the field.”

The badger became UW-Madison’s football mascot in 1889 but went nameless until about 1950, when a contest christened him Buckingham U. Badger. As best as can be determined, B. buckinghamii is the first organism named in Bucky’s honor, says Cindy Van Matre, trademark licensing director at UW-Madison.
Finding eight new species in one project was a fine haul, says Hittinger, an assistant professor of genetics, noting that this represents about one-half percent of all known yeast species. His new study is now online in the journal FEMS Yeast Research. (For more on Hittinger’s yeast work, see the cover story in the Spring 2015 issue of Grow magazine.)
Although it was lab manager Amanda Hulfachor who retrieved B. buckinghamii, Hittinger credits Kayla Sylvester, who started working in his lab as an undergraduate, as “our most prolific wild yeast hunter. She’s really gotten excited about pushing the boundary of what we know about yeasts in the wild, and has been exceptional in setting up and taking over the wild yeast sampling program.”
Sylvester, a native of Sussex, Wisconsin, admits she “didn’t give much thought to where yeasts came from until I came here. It’s hard to tell people you work with yeasts. They think of beer, bread or a yeast infection. They don’t think it would be found outside, but where else could yeasts come from?”
Avid collectors are only the first necessity for finding new yeasts, Hittinger adds. “Specialized enrichment and high-speed genetic sequencing were also key.” Enrichment starts by excluding other organisms, then growing pure colonies of the remaining yeast. Genetic sequencing solves a longstanding problem: yeasts vary little in appearance, even when they have radically different genes.
The lab work can be tedious, Sylvester admits, “but if you’re passionate, it’s very easy. If you are not passionate, it’s very hard. I am very passionate about what I am doing, making my job very enjoyable.”

Like the other fungi, yeasts specialize in decay, so yeast prospectors tend to sample dirt, rotting wood and bark. “A lot of early yeast collectors looked for fermenting sap,” says Hittinger, “but with appropriate enrichment, yeasts can be isolated directly from soil and rotting wood, without directly observing yeasts in the field.”
Yeasts are creative chemists. Hittinger notes that a single subphylum called Saccharomycotina contains more genetic diversity than all the vertebrate animals. That diversity gives them the ability to do more chemical transformations on the materials they consume.
The Saccharomyces yeasts metabolize sugar into alcohol, a compound that is poisonous to competing microbes. The alcohol makes wine, beer and the biofuel ethanol, while the carbon dioxide released raises bread.
Other yeasts have their own useful chemical tricks. “Some yeasts can accumulate half of their dry weight in oil, and that has more potential as a more advanced biofuel than ethanol,” Hittinger says.
Sylvester, who has graduated and is working in the Hittinger lab until she starts graduate school, says her experience has unleashed her curiosity. “Discovering eight new species is pretty cool. Everywhere you go, you sample. You start to develop all these questions: Does it matter what kind of tree you’re searching under? Does it matter if it’s close to a lake?”
Aside from Saccharomyces, most yeasts are poorly understood, Sylvester says. “You do the sequencing and get the genetic information. What makes this yeast species interesting? Once we get a big enough database, we can look for associations. Pattern-finding is fun; you can ask endless questions. That’s what I like. You can’t stop asking questions.”
This story was originally published on the UW-Madison News website.

